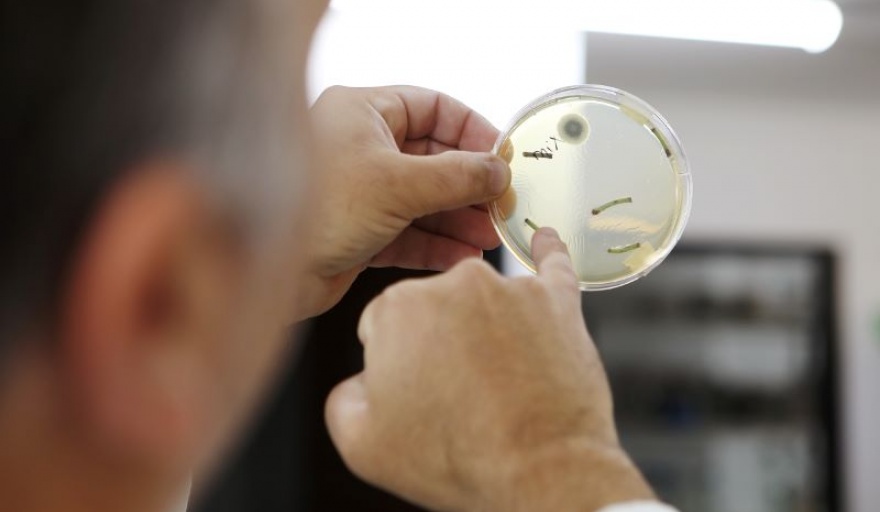

Científicos de la Universidad Nacional de La Plata desarrollaron un bioinsecticida a base de hongos que mejora el rendimiento de los cultivos. Los estudios se llevan adelante en el Instituto Spegazzini, División Micología, dependiente de la Facultad de Ciencias Naturales y Museo de la UNLP y de la Comisión de Investigaciones Científicas de la provincia de Buenos Aires.
El grupo de científicos trabaja con hongos entomopatógenos (es decir, hongos patógenos de insectos), con el objetivo de modificar las prácticas de la agricultura tradicional por otras más amigables con el ambiente, no contaminantes, y sin daños a la salud.
El Doctor en Ciencias Naturales y director del Spegazzini, Sebastián Pelizza, explicó que “actualmente trabajamos en un bioinsecticida en base a hongos entomopatógenos nativos, que tienen la capacidad de actuar de manera endofítica; esto significa que pueden ingresar y permanecer en el interior de los cultivos una vez que son aplicados sobre los mismos”.
Este bioinsectida en particular, como muchos otros productos biológicos, se puede aplicar con las mismas herramientas que utilizan usualmente los productores para esparcir los insecticidas químicos convencionales, con mochilas, mosquitos o avionetas fumigadoras.
Pelizza destacó que “la tecnología que hemos desarrollado fue validada en ensayos de laboratorio y en pequeños ensayos a campo sobre cultivos de soja y maíz. Allí observamos que la acción de estos hongos endófitos mejora considerablemente la sanidad vegetal de los cultivos, ya que produce un efecto de repelencia sobre los insectos plagas que atacan a la soja y el maíz”.
“Por otro lado, comprobamos en los ensayos a campo realizados hasta el momento que este grupo de microorganismos garantiza además en un mayor rendimiento medido en kilogramos por hectárea”, detalló.
Explicó que “esto se debe fundamentalmente a que los microorganismos presentes en el interior de los cultivos, ayudan a incorporar mayor cantidad de nutrientes por parte de los cultivos del suelo, ya que los descompone en partículas más pequeñas que luego las plantas pueden absorber con mayor eficiencia. Por otro lado, estos microorganismos sintetizan fitohormonas que benefician a la planta en términos de su desarrollo”.
Los resultados promisorios de los estudios permitieron que el grupo de trabajo del Spegazzini fuera seleccionado entre más de 80 proyectos (con 650 investigadores participantes), para recibir financiamiento de la compañía SF500, organismo que apoya y financia con capitales privados proyectos de investigación que tengan el potencial para la conformación de una StartUp.
“Es importante mencionar que la UNLP, a través de la incubadora de ideas Minerva, fue la que nos motivó y apoyó para que este proyecto salga exclusivamente del ámbito científico y académico y fuera en busca de inversiones privadas para el desarrollo de una empresa de base tecnológica”, remarcó Pelizza. (InfoGEI) Mg